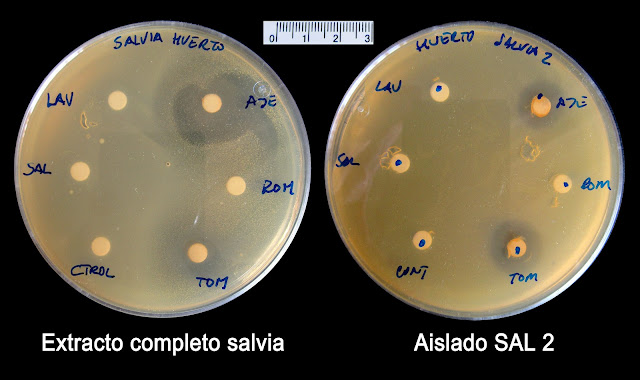

Ya tenemos los resultados de los experimentos preliminares que hemos hecho para comprobar si el diseño experimental era el adecuado. Hemos ensayado los extractos completos obtenidos de las diversas plantas así como de de los aislados que habíamos obtenidos.
Recordemos el procedimiento, aunque lo tenemos descrito en entradas anteriores. Sobre placas de Petri con medio TSA extendemos 5 ml de medio semisólido que habíamos inoculado con 100 microlitros de cultivos bien de extractos completos o de algunos aislados. Una vez solidificada esta capa se dispusieron sobre ella 6 discos de papel de filtro; a cada uno de ellos se le añadió 5 microlitros de cada uno de estos aceites esenciales: ajedrea, lavanda, romero, salvia y tomillo. El sexto no se impregnó de modo que actuase como control para desechar que los discos tuviesen algún tipo de efecto inhibidor del crecimiento.
La figura de arriba muestra el efecto de los aceites esenciales citados sobre el extracto completo de esparto y sobre dos colonias aisladas a partir de este. En el extracto completo aparecen discos de inhibición alrededor de los discos con aceites esenciales de ajedrea y tomillo. Los dos aislados muestran actividad importante frente a estos dos aceites y además, con menor intensidad en la lavanda y la salvia. El aceite de romero no parece tener efecto sobre estos microorganismos.
En la imagen de arriba se compara el efecto de los aceites sobre los extractos completos de romero, de plantas procedentes de Órgiva (recolectadas por María Ángeles) y de romero de nuestro huerto. En este último caso, podemos apreciar dos tipos de colonias que crecen alrededor de los discos con aceite de ajedrea y tomillo, una más sensible que otra.
La imagen de arriba muestra la sensibilidad de las bacterias de los extractos de tomillo de Órgiva a los distintos aceites esenciales. Hemos ensayado también algunos de los aislados individuales de este extracto, aunque no nos han crecido hasta ahora. Las hemos dejado incubando fuera de la estufa, a la vuelta de vacaciones veremos si hay resultados.
La imagen de arriba muestra el carácter inhibidor de los aceites esenciales sobre el extracto completo de lavanda de nuestro huerto y de dos aislados, el LAV1 y el LAV 2. Como muestran las imágenes hay gran diferencia entre la sensibilidad en estos dos aislados.
Tenemos también resultados de la salvia de nuestro huerto, tanto del extracto completo como del aislado SAL 2. Igualmente son sensibles a los aceites de ajedrea y tomillo. En este caso me quedan mis dudas de que hayamos intercambiado los rótulos de las placas, o lo que es igual, que hayamos cambiado las bacterias con las que hemos inoculado las placas.
De las hojas de haba y de hiedra recolectadas en nuestro instituto aislamos de cada una de ellas un microorganismo que daba lugar a crecimientos muy similares y que resultaban muy invasivo extendiéndose con mucha facilidad por las placas. Como se puede apreciar, son muy sensibles a algunos de los aceites esenciales.
Por último, y por ahora, mostramos el efecto inhibidos de los aceites sobre un microorganismo aislado de las hojas del naranjo (NAR 1). En este caso también hay un efecto muy importante del tomillo, la ajedrea, y en menor cantidad de aceite de lavanda y de salvia.
A la vuelta de vacaciones repetiremos estos experimentos con placas que está preparando María Ángeles. Las traerá preparadas para que únicamente añadamos los aceites esenciales y las incubemos. Pero mientras tanto podemos ir haciendo un análisis de nuestros resultados e intentar responder a preguntas como cuál pensáis vosotros que es el aceite esencial con mayor potencial antimicrobiano, cómo los ordenaríais de mayor a menor actividad, o si veis diferencias entre la sensibilidad de los extractos completos y los de aislados específicos.
Los resultados nos están acompañando un proyecto que está resultando maravilloso. Pero lo que lo hace verdaderamente bonito es vuestra participación. En el párrafo anterior os he hecho algunas sugerencias, pero lo importante es que analicéis nuestros resultados y comentéis lo que os sugieran. Y lo más importante, esto es un proyecto de todos y entre todos debemos compartir nuestras ideas en los comentarios.